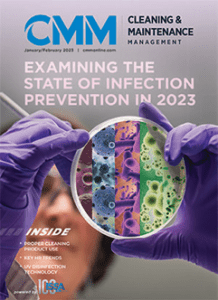
{{brizy_dc_image_alt entityId=

Mike in the Media - Posts, Articles, Interviews & More
Get the best available information on cleaning and supply efficiencies available
Articles by Mike Sawchuk

The importance of high-quality data. Why is it one of the five key pillars that will drive significant, long-term improvements in cleaning operations?

How to maximize results of your cleaning operations – 5 Key Pillars that will drive significant, long-term improvement and enable cleaning operations to meet higher client expectations while providing the highest levels of clean, safe, and healthy at the lowest overall cost.
- 1
- 2
Podcasts Including Mike Sawchuk
Videos Including Mike Sawchuk

Making LinkedIn Work For Distributor Salespeople (Pt. 2): How Do We Know It’s Effective?

Find Mike on Social Media:
Have a Quick Question?
©copyright 2025 Sawchuk Consulting. This site is built & maintained by Pilgrim Consulting & Design